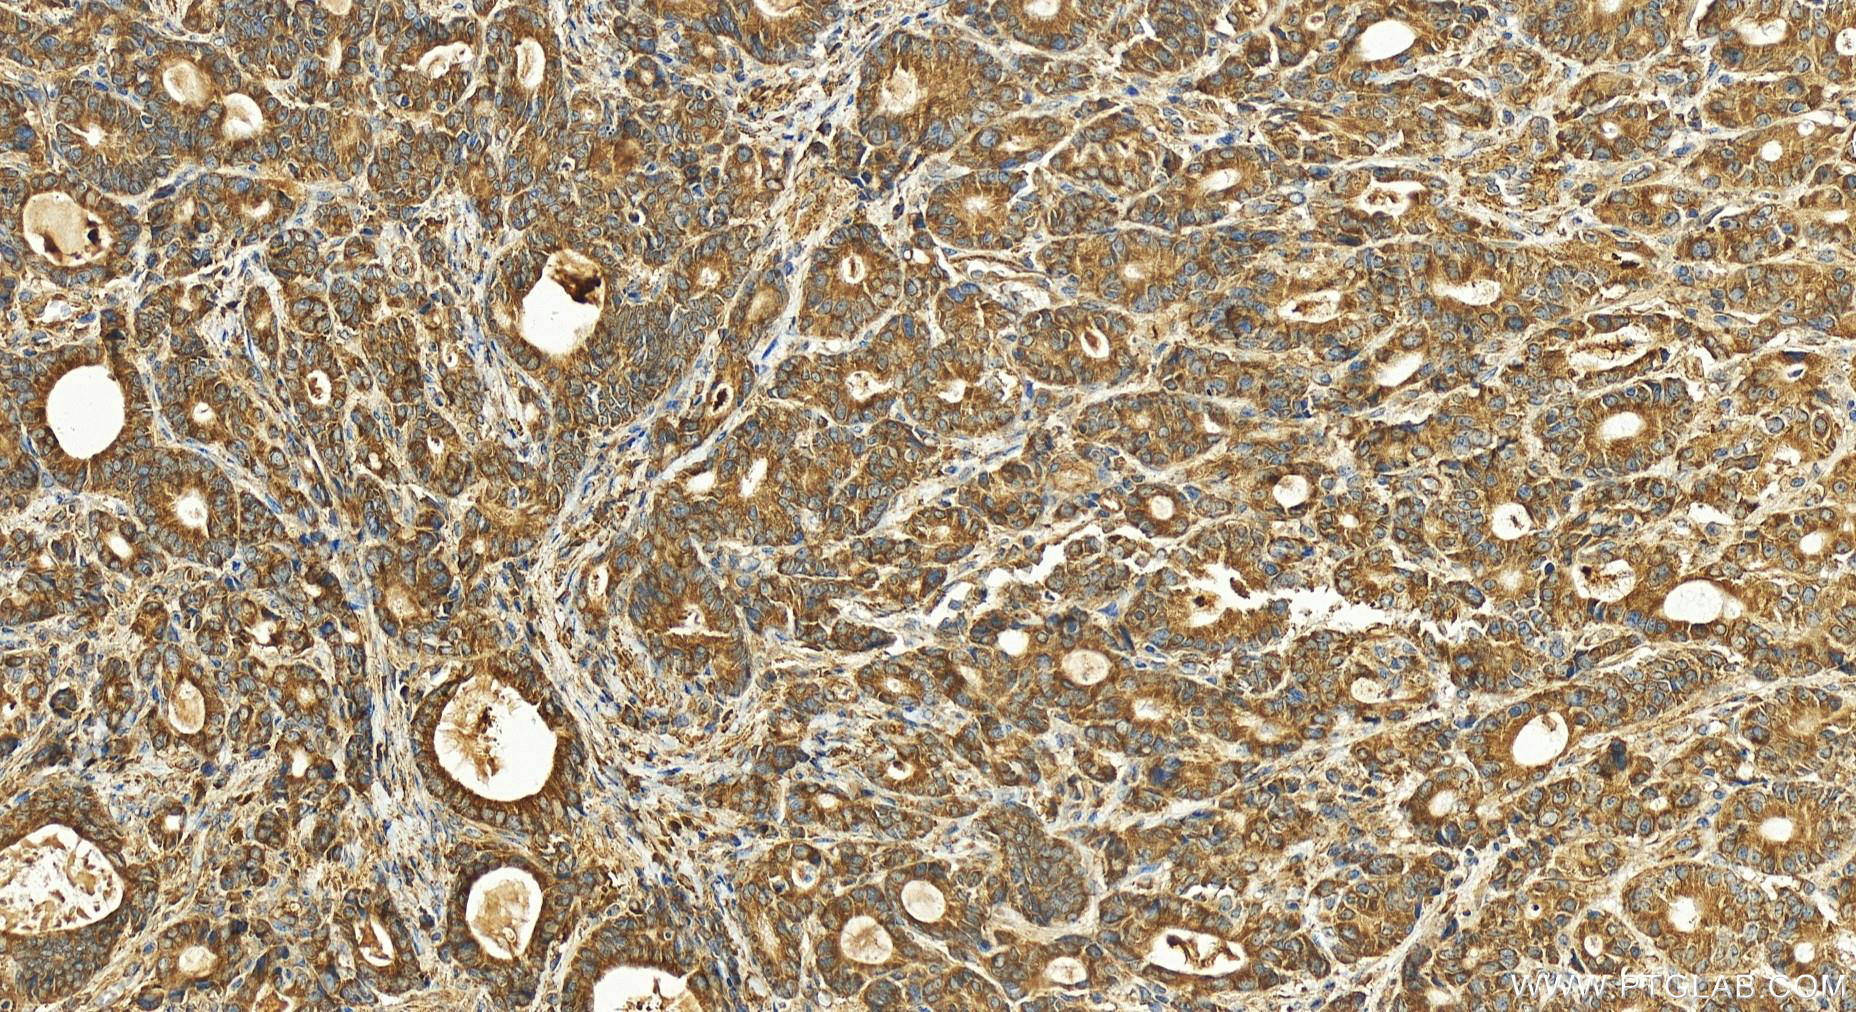

验证数据展示
经过测试的应用
| Positive WB detected in | HEK-293 cells, HuH-7 cells, MNK-45 cells, SGC-7901 cells, LNCaP cells |
| Positive IHC detected in | human stomach cancer tissue Note: suggested antigen retrieval with TE buffer pH 9.0; (*) Alternatively, antigen retrieval may be performed with citrate buffer pH 6.0 |
推荐稀释比
| 应用 | 推荐稀释比 |
|---|---|
| Western Blot (WB) | WB : 1:2000-1:10000 |
| Immunohistochemistry (IHC) | IHC : 1:50-1:500 |
| It is recommended that this reagent should be titrated in each testing system to obtain optimal results. | |
| Sample-dependent, Check data in validation data gallery. | |
产品信息
20710-1-AP targets ACSL3 in WB, IHC, IF, ELISA applications and shows reactivity with human, mouse samples.
| 经测试应用 | WB, IHC, ELISA Application Description |
| 文献引用应用 | WB, IHC, IF |
| 经测试反应性 | human, mouse |
| 文献引用反应性 | human, mouse |
| 免疫原 |
Peptide 种属同源性预测 |
| 宿主/亚型 | Rabbit / IgG |
| 抗体类别 | Polyclonal |
| 产品类型 | Antibody |
| 全称 | acyl-CoA synthetase long-chain family member 3 |
| 别名 | ACS3, ACSL 3, Arachidonate--CoA ligase, EC:6.2.1.15, EC:6.2.1.2 |
| 计算分子量 | 80 kDa |
| 观测分子量 | 70-80 kDa |
| GenBank蛋白编号 | NM_004457 |
| 基因名称 | ACSL3 |
| Gene ID (NCBI) | 2181 |
| RRID | AB_10697670 |
| 偶联类型 | Unconjugated |
| 形式 | Liquid |
| 纯化方式 | Antigen affinity purification |
| UNIPROT ID | O95573 |
| 储存缓冲液 | PBS with 0.02% sodium azide and 50% glycerol, pH 7.3. |
| 储存条件 | Store at -20°C. Stable for one year after shipment. Aliquoting is unnecessary for -20oC storage. |
背景介绍
ACSL3, also named as ACS3, FACL3 and LACS3, belongs to the ATP-dependent AMP-binding enzyme family. Acyl-CoA synthetases (ACSL) activate long-chain fatty acids for both synthesis of cellular lipids, and degradation via beta-oxidation. ACSL3 mediates hepatic lipogenesis. Preferentially uses myristate, laurate, arachidonate and eicosapentaenoate as substrates. Has mainly an anabolic role in energy metabolism. Required for the incorporation of fatty acids into phosphatidylcholine, the major phospholipid located on the surface of VLDL (very low density lipoproteins). The antibody is specific to ACSL3.
实验方案
| Product Specific Protocols | |
|---|---|
| IHC protocol for ACSL3 antibody 20710-1-AP | Download protocol |
| WB protocol for ACSL3 antibody 20710-1-AP | Download protocol |
| Standard Protocols | |
|---|---|
| Click here to view our Standard Protocols |
发表文章
| Species | Application | Title |
|---|---|---|
Cancer Commun (Lond) Blockage of EGFR/AKT and mevalonate pathways synergize the antitumor effect of temozolomide by reprogramming energy metabolism in glioblastoma | ||
Free Radic Biol Med Role of ferroptosis mediated by abnormal membrane structure in DEHP-induced reproductive injury | ||
Clin Transl Med NAT10: An RNA cytidine transferase regulates fatty acid metabolism in cancer cells | ||
Anal Chem Ionic Liquid-Based Extraction System for In-Depth Analysis of Membrane Protein Complexes. | ||
Biochim Biophys Acta Mol Cell Biol Lipids Rab18 binds PLIN2 and ACSL3 to mediate lipid droplet dynamics. |